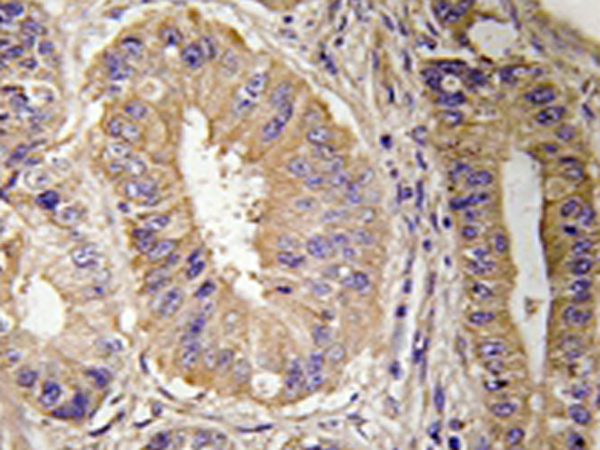
一抗

中文名稱 : 兔抗PTK2(Ab-843) 多克隆抗體
英文名稱 : Anti-PTK2(Ab-843) rabbit polyclonal antibody
別 名 : FAK; FADK; FAK1; FRNK; PPP1R71; p125FAK; pp125FAK
儲 存 : 冷凍(-20℃) 避光
抗 原 : PTK2(Ab-843)
宿 主 : Rabbit
反應種屬 : Human
相關類別 : 一抗
標 記 物 : Unconjugate
克隆類型 : rabbit polyclonal
技術規(guī)格
|
Background: |
This gene encodes a cytoplasmic protein tyrosine kinase which is found concentrated in the focal adhesions that form between cells growing in the presence of extracellular matrix constituents. The encoded protein is a member of the FAK subfamily of protein tyrosine kinases but lacks significant sequence similarity to kinases from other subfamilies. |
|
Applications: |
WB, IHC |
|
Name of antibody: |
PTK2(Ab-843) |
|
Immunogen: |
Synthesized peptide derived from Internal of human FAK. |
|
Full name: |
protein tyrosine kinase 2 |
|
Synonyms: |
FAK; FADK; FAK1; FRNK; PPP1R71; p125FAK; pp125FAK |
|
SwissProt: |
Q05397 |
|
IHC positive control: |
Human colon carcinoma tissue |
|
IHC Recommend dilution: |
50-100 |
|
WB Predicted band size: |
119 kDa |
|
WB Positive control: |
Huvec cells and MCF7 cells lysates |
|
WB Recommended dilution: |
500-3000 |


 購物車
購物車 幫助
幫助
 021-54845833/15800441009
021-54845833/15800441009